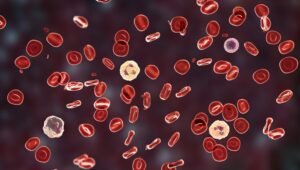

Our Latest Videos

Raj Kumar Gupta’s blog is dedicated to providing reliable and easy-to-understand information on medical topics. Our goal is to help readers stay informed about health, medicines, and wellness with clear and trustworthy content.
© Copyright 2011 | Raj Kumar Gupta Blogs | All Right Reserved , Collected By Rajkumar Gupta.